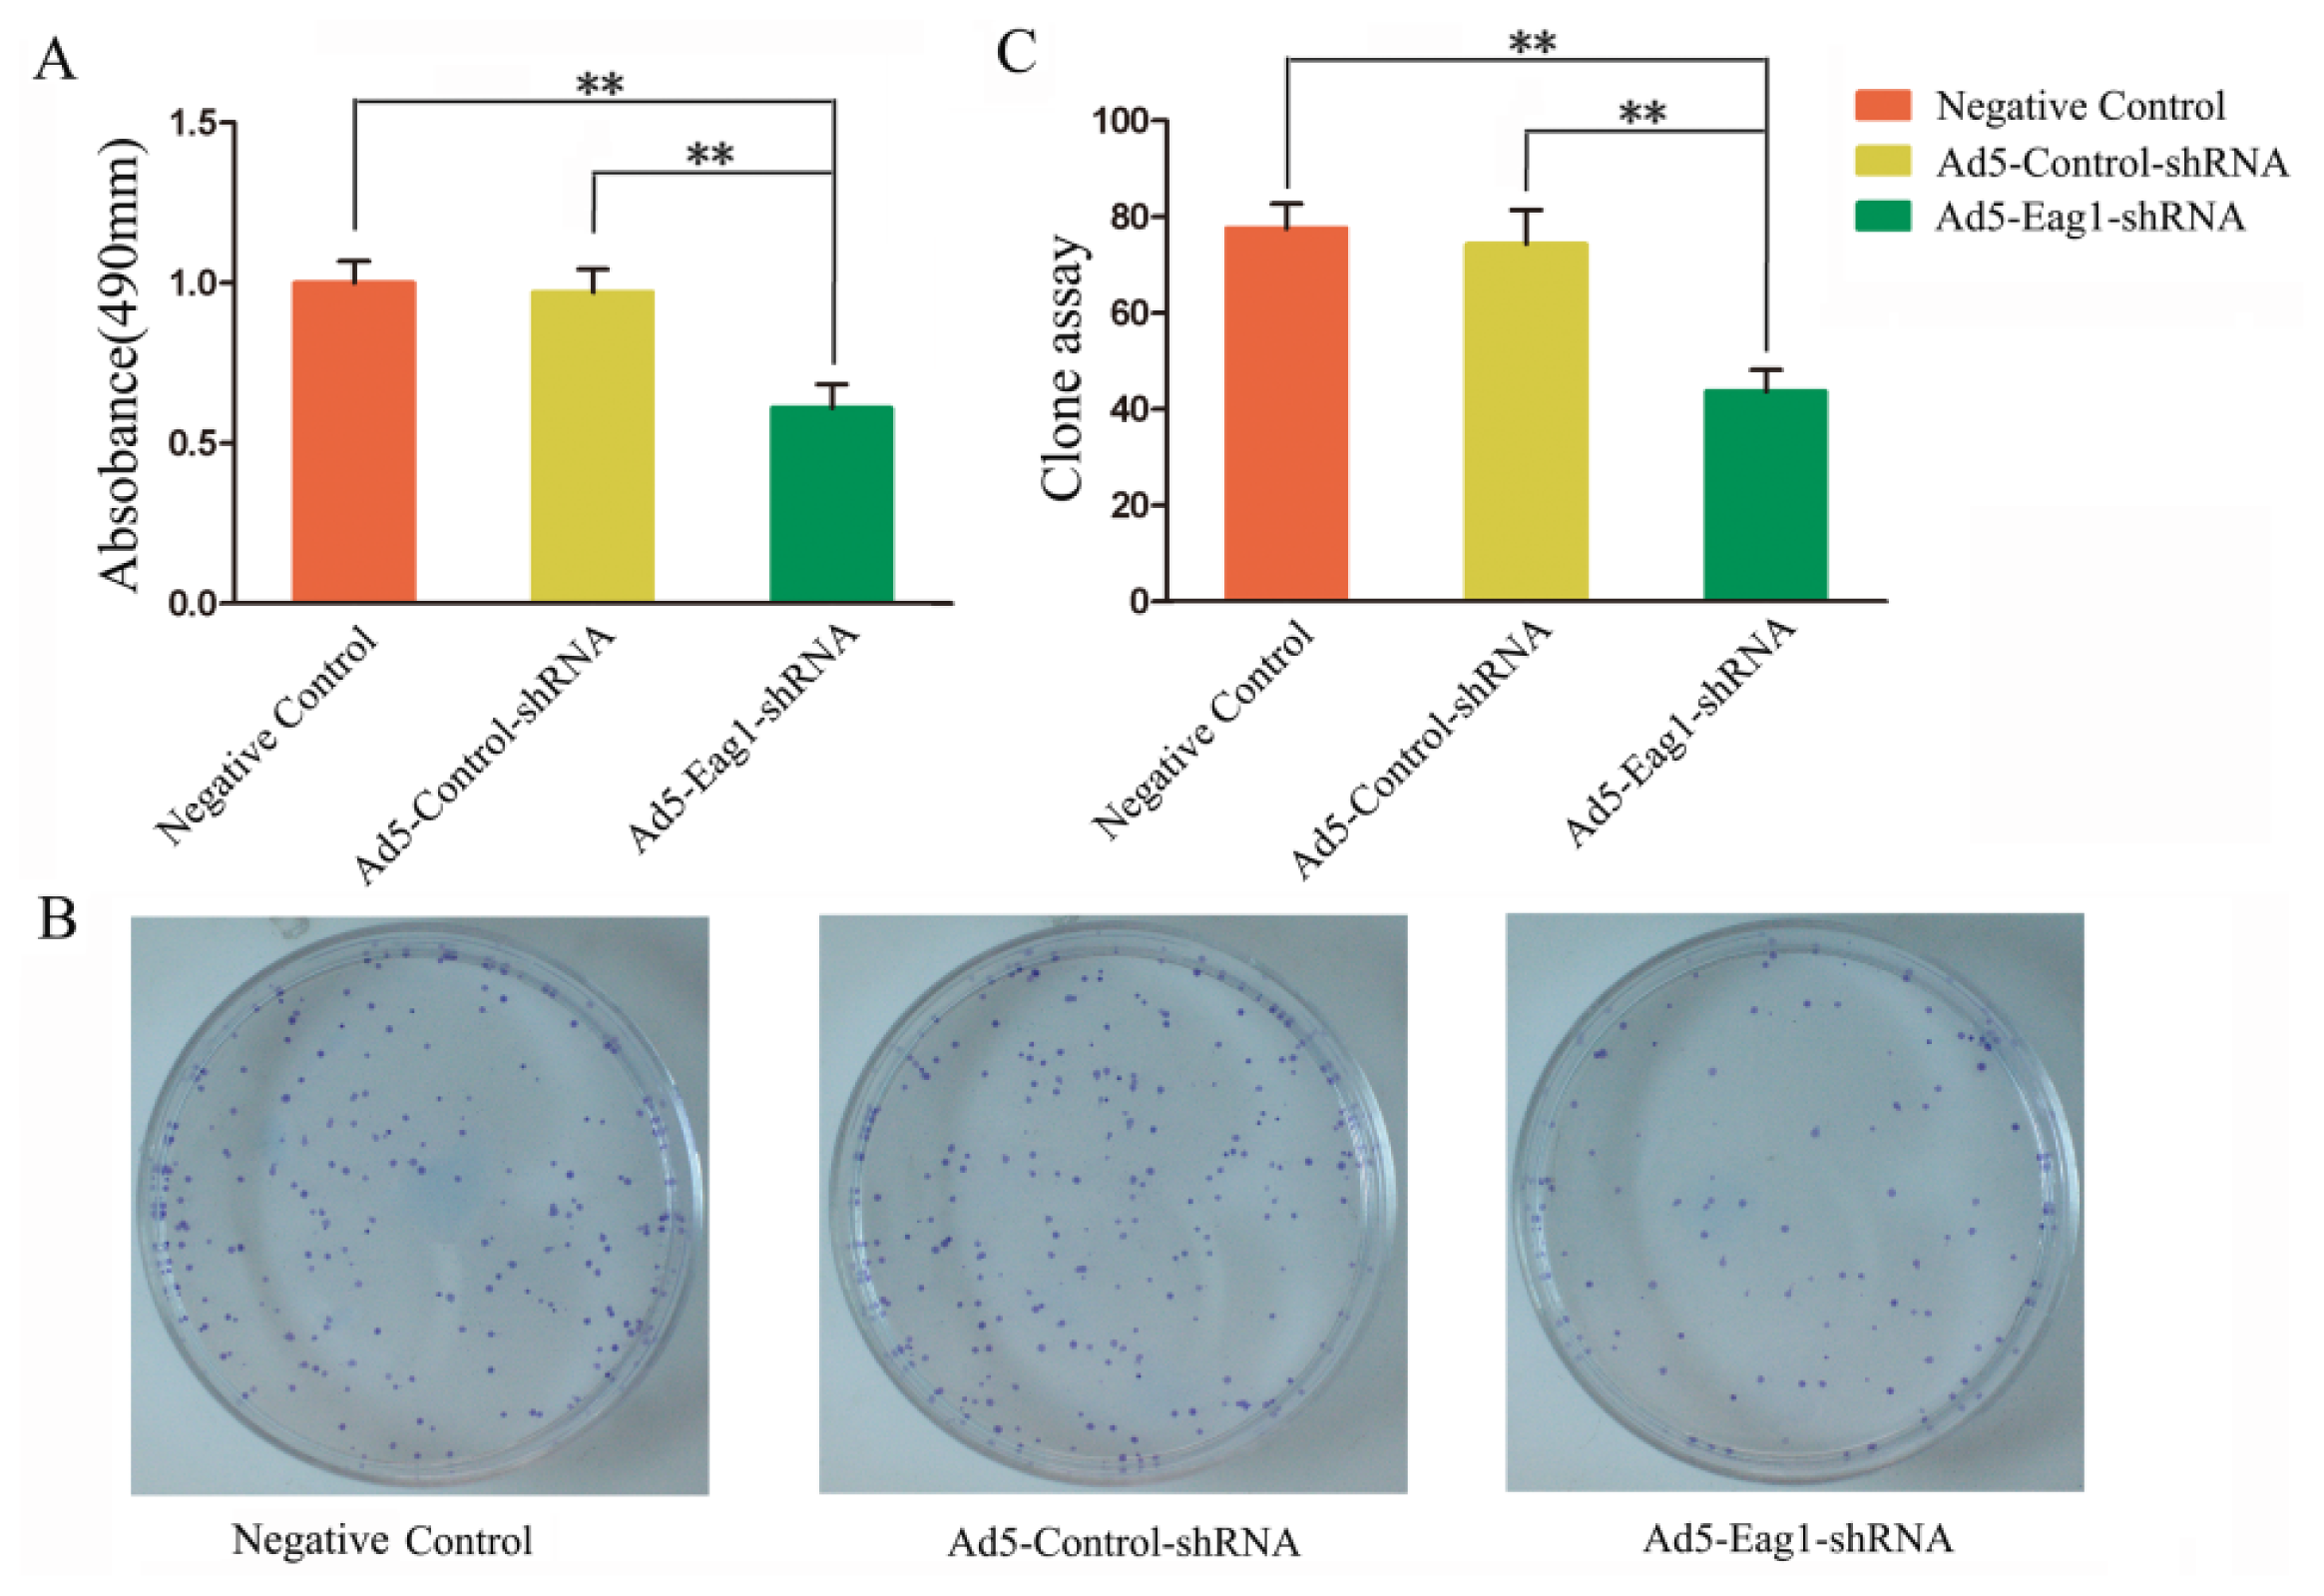

Silencing of Ether à Go-Go 1 by shRNA Inhibits Osteosarcoma Growth and Cell Cycle Progression
Abstract
:1. Introduction
2. Results
2.1. Ad5-Eag1-shRNA Inhibits Eag1 Expression in MG-63 Cells
2.2. Ad5-Eag1-shRNA Inhibits MG-63 Cell Proliferation
2.3. Ad5-Eag1-shRNA Inhibits Tumor Growth in a Xenograft Model of OS
2.4. Ad5-Eag1-shRNA Inhibits Cell Cycle Progression of MG-63 Cells
2.5. Eag1 Regulates the Expression of Cell Cycle Related Proteins in MG-63 Cells
3. Discussion
4. Materials and Methods
4.1. Cell Culture
4.3. Adenovirus Infection
4.4. RT-PCR
4.5. Western Blot Analysis
4.6. Cell Proliferation Assay
4.7. Colony Formation Assay
4.8. Tumorigenicity Assay in Nude Mice
4.9. Flow Cytometry Analysis
4.10. Statistical Analysis
5. Conclusions
Acknowledgments
Conflicts of Interest
References
- Damron, T.A.; Ward, W.G.; Stewart, A. Osteosarcoma, chondrosarcoma, and Ewing’s sarcoma: National cancer data base report. Clin. Orthop. Relat. Res 2007, 459, 40–47. [Google Scholar]
- Sluga, M.; Windhager, R.; Pfeiffer, M.; Ofner, P.; Lang, S.; Dominkus, M.; Nehrer, S.; Zoubek, A.; Kotz, R. Osteosarcoma and Ewing’s sarcoma-The most frequent malignant bone tumors in children-therapy and outcome. Z. Orthop. Ihre Grenzgeb 2002, 140, 652–655. [Google Scholar]
- Klein, M.J.; Siegal, G.P. Osteosarcoma: Anatomic and histologic variants. Am. J. Clin. Pathol 2006, 125, 555–581. [Google Scholar]
- Benayahu, D.; Shur, I.; Marom, R.; Meller, I.; Issakov, J. Cellular and molecular properties associated with osteosarcoma cells. J. Cell Biochem 2001, 84, 108–114. [Google Scholar]
- Panizo-Santos, A.; Sola, I.; Lozano, M.; de Alava, E.; Pardo, J. Metastatic osteosarcoma presenting as a small bowel polyp: A case report and review of the literature. Arch. Pathol. Lab. Med 2000, 124, 1682–1684. [Google Scholar]
- Hawkins, D.S.; Arndt, C.A. Pattern of disease recurrence and prognostic factors in patients with osteosarcoma treated with contemporary chemotherapy. Cancer 2003, 98, 2447–2456. [Google Scholar]
- Wu, P.K.; Chen, W.M.; Chen, C.F.; Lee, O.K.; Haung, C.K.; Chen, T.H. Primary osteogenic sarcoma with pulmonary metastasis: Clinical results and prognostic factors in 91 patients. Jpn. J. Clin. Oncol 2009, 39, 514–522. [Google Scholar]
- Tan, M.L.; Choong, P.F.; Dass, C.R. Osteosarcoma: Conventional treatment vs. gene therapy. Cancer Biol. Ther 2009, 8, 106–117. [Google Scholar]
- Pardo, L.A.; Contreras-Jurado, C.; Zientkowska, M.; Alves, F.; Stuhmer, W. Role of voltage-gated potassium channels in cancer. J. Membr. Biol 2005, 205, 115–124. [Google Scholar]
- Kaplan, W.D.; Trout, W.E., 3rd. The behavior of four neurological mutants ofDrosophila. Genetics 1969, 61, 399–409. [Google Scholar]
- Warmke, J.W.; Ganetzky, B. A family of potassium channel genes related to eag in Drosophila and mammals. Proc. Natl. Acad. Sci. USA 1994, 91, 3438–3442. [Google Scholar]
- Bauer, C.K.; Schwarz, J.R. Physiology of EAG K+ channels. J. Membr. Biol 2001, 182, 1–15. [Google Scholar]
- Camacho, J. Ether à go-go potassium channels and cancer. Cancer Lett 2006, 233, 1–9. [Google Scholar]
- Hemmerlein, B.; Weseloh, R.M.; de Queiroz, F.M.; Knötgen, H.; Sánchez, A.; Rubio, M.E.; Martin, S.; Schliephacke, T.; Jenke, M.; Radzun, H.J.; et al. Overexpression of Eag1 potassium channels in clinical tumours. Mol. Cancer 2006, 5, 41. [Google Scholar]
- De Queiroz, F.M.; Suarez-Kurtz, G.; Stühmer, W.; Pardo, L.A. Ether à go-go potassium channel expression in soft tissue sarcoma patients. Mol. Cancer 2006, 5, 42. [Google Scholar]
- Weber, C.; de Queiroz, F.M.; Downie, B.R.; Suckow, A.; Stühmer, W.; Pardo, L.A. Silencing the activity and proliferative properties of the human EagI potassium channel by RNA interference. J. Biol. Chem 2006, 281, 13030–13037. [Google Scholar]
- Pardo, L.A.; del Camino, D.; Sánchez, A.; Alves, F.; Brüggemann, A.; Beckh, S.; Stühmer, W. Oncogenic potential of EAG K+ channels. EMBO J 1999, 18, 5540–5547. [Google Scholar]
- Downie, B.R.; Sánchez, A.; Knötgen, H.; Contreras-Jurado, C.; Gymnopoulos, M.; Weber, C.; Stühmer, W.; Pardo, L.A. Eag1 expression interferes with hypoxia homeostasis and induces angiogenesis in tumors. J. Biol. Chem 2008, 283, 36234–36240. [Google Scholar]
- Wu, J.; Wu, X.; Zhong, D.; Zhai, W.; Ding, Z.; Zhou, Y. Short hairpin RNA (shRNA) ether à go-go 1 (Eag1) inhibition of human osteosarcoma angiogenesis via VEGF/PI3K/AKT signaling. Int. J. Mol. Sci 2012, 13, 12573–12583. [Google Scholar]
- Wu, X.; Zhong, D.; Gao, Q.; Zhai, W.; Ding, Z.; Wu, J. MicroRNA-34a inhibits human osteosarcoma proliferation by downregulating ether à go-go 1 expression. Int. J. Med. Sci 2013, 10, 676–682. [Google Scholar]
- García-Ferreiro, R.E.; Kerschensteiner, D.; Major, F.; Monje, F.; Stühmer, W.; Pardo, L.A. Mechanism of block of hEag1 K+ channels by imipramine and astemizole. J. Gen. Physiol 2004, 124, 301–317. [Google Scholar]
- Gómez-Varela, D.; Zwick-Wallasch, E.; Knötgen, H.; Sánchez, A.; Hettmann, T.; Ossipov, D.; Weseloh, R.; Contreras-Jurado, C.; Rothe, M.; Stühmer, W.; et al. Monoclonal antibody blockade of the human Eag1 potassium channel function exerts antitumor activity. Cancer Res 2007, 67, 7343–7349. [Google Scholar]
- Pardo, L.A.; Stühmer, W. Eag1 as a cancer target. Expert Opin. Ther. Targets 2008, 12, 837–843. [Google Scholar]
- Wu, X.; Zhong, D.; Lin, B.; Zhai, W.; Ding, Z.; Wu, J. p38 MAPK regulates the expression of ether à go-go potassium channel in human osteosarcoma cells. Radiol. Oncol 2013, 47, 42–49. [Google Scholar]
- Pardo, L.A.; Brüggemann, A.; Camacho, J.; Stühmer, W. Cell cycle-related changes in the conducting properties of r-eag K+ channels. J. Cell Biol 1998, 143, 767–775. [Google Scholar]
- Galderisi, U.; Jori, F.P.; Giordano, A. Cell cycle regulation and neural differentiation. Oncogene 2003, 22, 5208–5219. [Google Scholar]
- Deshpande, A.; Sicinski, P.; Hinds, P.W. Cyclins and cdks in development and cancer: A perspective. Oncogene 2005, 24, 2909–2915. [Google Scholar]
- Malumbres, M. Cyclins and related kinases in cancer cells. J. BUON 2007, 12, S45–S52. [Google Scholar]
- Drobnjak, M.; Osman, I.; Scher, H.I.; Fazzari, M.; Cordon-Cardo, C. Overexpression of cyclin D1 is associated with metastatic prostate cancer to bone. Clin. Cancer Res 2000, 6, 1891–1895. [Google Scholar]
- Borowiec, A.S.; Hague, F.; Gouilleux-Gruart, V.; Lassoued, K.; Ouadid-Ahidouch, H. Regulation of IGF-1-dependent cyclin D1 and E expression by hEag1 channels in MCF-7 cells: The critical role of hEag1 channels in G1 phase progression. Biochim. Biophys. Acta 2011, 1813, 723–730. [Google Scholar]
- Zhang, Y.Y.; Yue, J.; Che, H.; Sun, H.Y.; Tse, H.F.; Li, G.R. BKCa and hEag1 channels regulate cell proliferation and differentiation in human bone marrow-derived mesenchymal stem cells. J. Cell. Physiol 2014, 229, 202–212. [Google Scholar]
- Miwa, S.; Sugimoto, N.; Yamamoto, N.; Shirai, T.; Nishida, H.; Hayashi, K.; Kimura, H.; Takeuchi, A.; Igarashi, K.; Yachie, A.; et al. Caffeine induces apoptosis of osteosarcoma cells by inhibiting AKT/mTOR/S6K, NF-κB and MAPK pathways. Anticancer Res 2012, 32, 3643–3649. [Google Scholar]

© 2014 by the authors; licensee MDPI, Basel, Switzerland This article is an open access article distributed under the terms and conditions of the Creative Commons Attribution license (http://creativecommons.org/licenses/by/3.0/).
Share and Cite
Wu, J.; Zhong, D.; Fu, X.; Liu, Q.; Kang, L.; Ding, Z. Silencing of Ether à Go-Go 1 by shRNA Inhibits Osteosarcoma Growth and Cell Cycle Progression. Int. J. Mol. Sci. 2014, 15, 5570-5581. https://doi.org/10.3390/ijms15045570
Wu J, Zhong D, Fu X, Liu Q, Kang L, Ding Z. Silencing of Ether à Go-Go 1 by shRNA Inhibits Osteosarcoma Growth and Cell Cycle Progression. International Journal of Molecular Sciences. 2014; 15(4):5570-5581. https://doi.org/10.3390/ijms15045570
Chicago/Turabian StyleWu, Jin, Daixing Zhong, Xijin Fu, Qingjun Liu, Liangqi Kang, and Zhenqi Ding. 2014. "Silencing of Ether à Go-Go 1 by shRNA Inhibits Osteosarcoma Growth and Cell Cycle Progression" International Journal of Molecular Sciences 15, no. 4: 5570-5581. https://doi.org/10.3390/ijms15045570
APA StyleWu, J., Zhong, D., Fu, X., Liu, Q., Kang, L., & Ding, Z. (2014). Silencing of Ether à Go-Go 1 by shRNA Inhibits Osteosarcoma Growth and Cell Cycle Progression. International Journal of Molecular Sciences, 15(4), 5570-5581. https://doi.org/10.3390/ijms15045570
